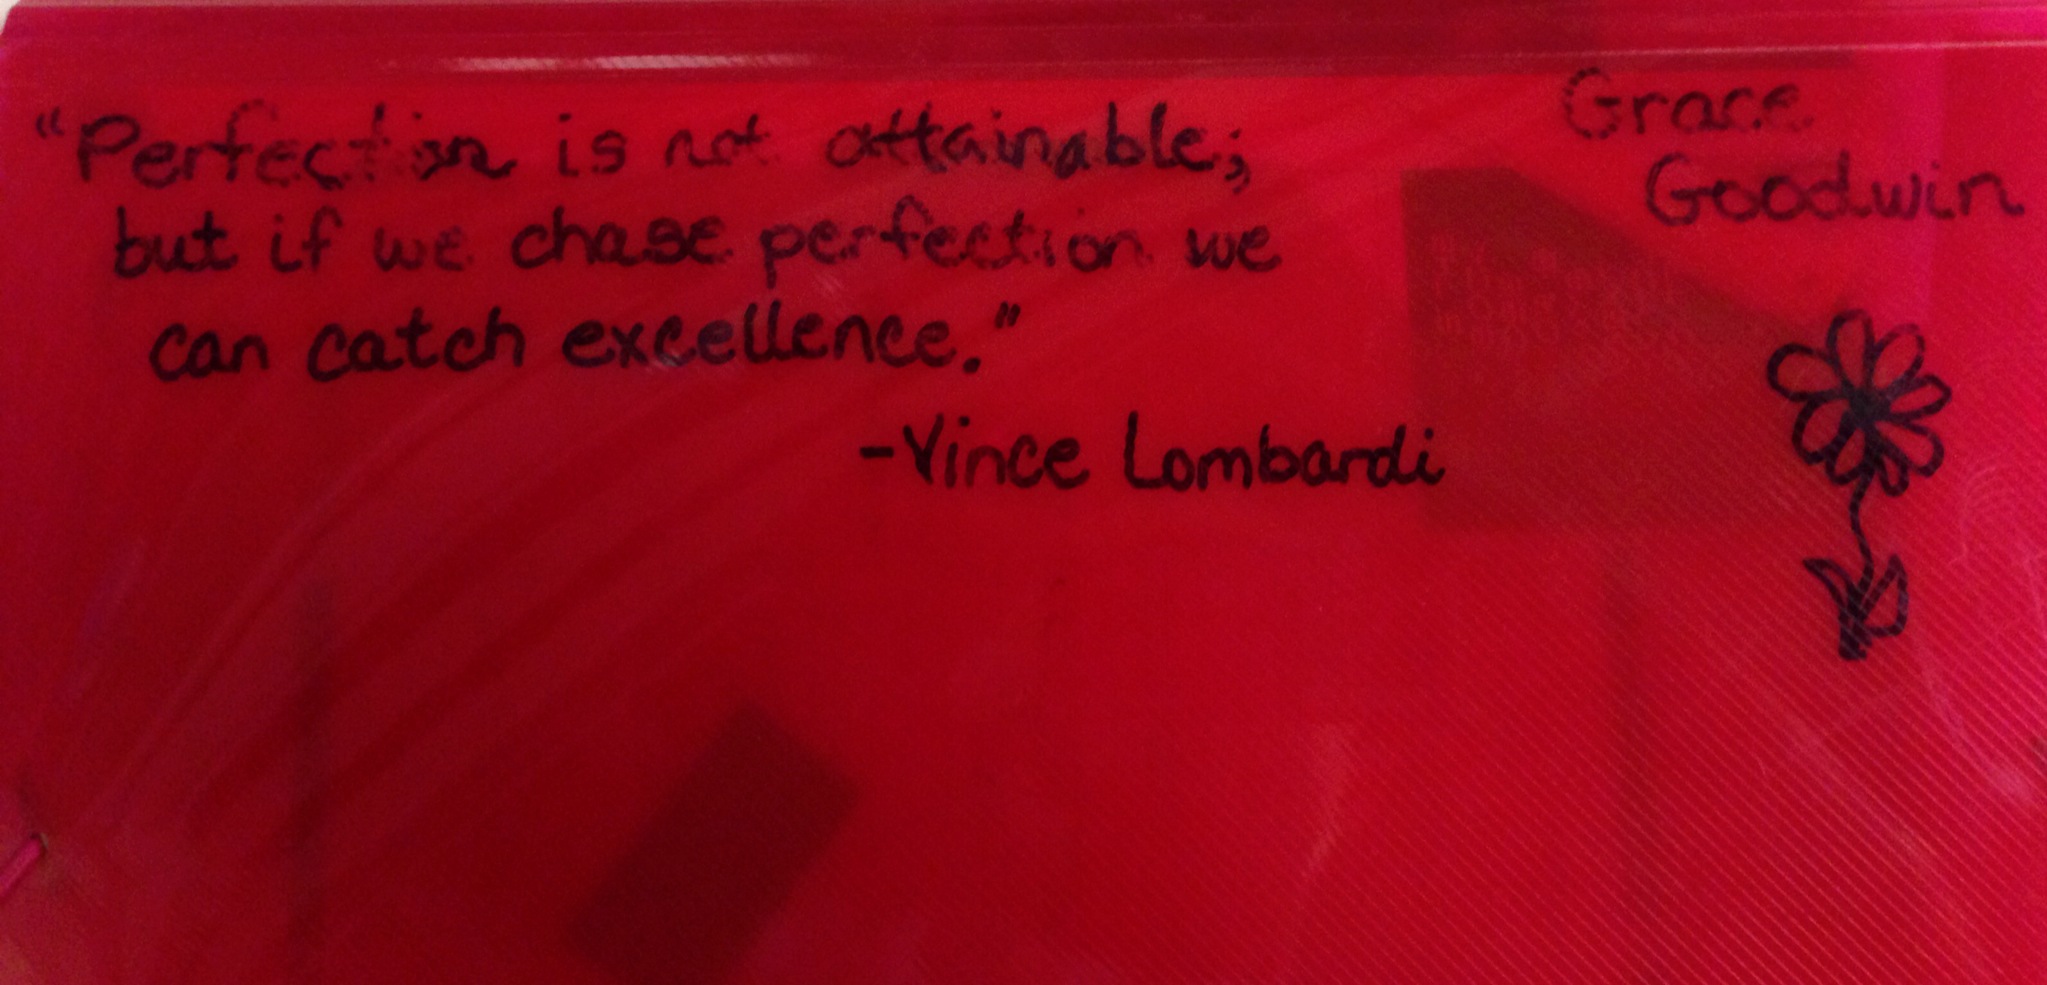

As a young pre-pubescent tween girl of the Seventies, it was almost a rite of passage to read the ever-popular book “Are You There God? It’s Me Margaret” by Judy Blume. It was a story about a girl writing letters in her journal discussing the impending arrival of her period. Gasp!!! There, I said it! For some reason, the word “period” or “menstruation” has always been one of those words that makes people uncomfortable, particularly teenagers once they know what it means.

I am going to talk about another word that surprisingly makes people uncomfortable. No it isn’t the “f-bomb”! I discussed my thoughts on that in an earlier post. For some reason, which is beyond me, this word has become so out-of-bounds naughty to some, it actually makes them vicious and hateful. Others, especially those who have become shackled by political correctness, whisper it and talk about it with such sensitivity you would think it a vulgarity. The word is GOD. There, I said it! What a potty mouth!!!!!
A few weeks ago, my daughter and I met my husband for dinner after we had all had a very long day. He looked especially tired and told me that he started his day in the Hamilton County courtroom in Cincinnati. He was there as an observer because he was selected to be part of a team utilizing their proven leadership skills to create collaborative initiatives focused on improving the city. He showed me a picture of a guy that had been arraigned and had had his bond set because he had allegedly robbed and murdered someone. Showing me a picture he pulled up from the Internet, he said, “Look at his eyes.” The eyes of the man in the photo were dark, soul-less, abysmal pools. We then touched on the large number of criminals that had gone before the judge while he was there. One every minute or two. It was like an assembly line. The name was called, the bond was set, the judged stamped their paper and said, “Next.”
He was telling me how depressing it was to see so many lost souls, and how they just keep cycling back through the system because they don’t know a better way. The jails are overcrowded, so if it is anything other than a major offense, they pretty much walk. He said that in most of these situations there is no father in the picture, and if they are hungry, they might have to steal. In white suburbia, he told me, we just can’t imagine what that is like. SCREEEEEEEECH!!!!! Hold on just a minute! I hardly think hunger is the main source of the crimes committed. “The problem is so big, there really isn’t a solution.” Really??? Hellur….GOD? He’s pretty big!
I once saw a quote,”Don’t tell God you have a big problem, tell your problem you have a big God.” I am not going to beat the Bible over anyone’s head here, but I believe a quick reference guide for “Top 10 Ways to Stay Out of Jail” can easily be found in Exodus 20….a.k.a. The Ten Commandments. Now, I am no theologian, but the Bible talks about the wilderness, and I am pretty darn certain that if you follow these simple instructions, you will stay away from the depravity..just sayin’!

There are initiatives, welfare programs, studies, and data created in an effort to treat the epidemic, but why not be proactive in staving off poverty. If one knew there was a deadly disease, and one could be vaccinated to prevent it, wouldn’t one opt for the shot instead of hoping the body would fight the contagion? My question is why haven’t all these so-called specialists interested in fighting poverty ever blamed the removal of prayer from schools…the breakdown of families…the low number of people attending church? It seems like such an obvious answer. President Lyndon B. Johnson’s Great Society was supposed to be a “war on poverty”. As one can see from the image below, $22 TRILLION has been spent and we are NO BETTER OFF!!!

Two years prior to launching The Great Society, prayer was taken out of school. Here is a photo taken in the Fifties of children saying prayer in school:

In his book “America: To Pray or not to Pray”, David Barton lists some staggering statistics:
Since the 1962 removal of prayer:
SAT Total Scores

CASES OF SEXUALLY TRANSMITTED DISEASES
Includes: Gonorrhea, Syphillis, Chancroid,
Granuloma Inguinale, Lymphgranuloma Venereum, and AIDS

PREGNANCIES TO UNWED GIRLS
Under 15 Years of Age

PREGNANCIES TO UNWED GIRLS
Under 15-19 Years of Age

BIRTH RATES FOR UNWED GIRLS
Under 15-19 Years of Age

PRE-MARITAL SEX
Percentage of U.S. Teenage Girls
Who Have Had Pre-Marital Intercourse

SINGLE PARENT HOUSEHOLDS
Female Head, No Spouse Present

UNMARRIED COUPLES LIVING TOGETHER

YEAR
Prior to 1977, unmarried couples living together was such a small group that data on this group was collected only in the 10-year census reports.* Note: Unmarried couples represented only 1 in 85 of all couples in 1970,
compared with 1 in 25 in 1983. Basic data from Statistical Abstracts of the United States
DIVORCE RATES

“The U.S. is at the top of the world’s divorce charts on marital breakups.”
U.S. News and World Report, June 8, 1987, pp. 68-69
“The number of divorces tripled each year between 1962 and 1981.”
Time, July 13, 1987, p. 21
ALCOHOL CONSUMPTION PER CAPITA

VIOLENT CRIME: Number of Offenses

Amazingly, if one studies the Liberal Progressive movement, it abhors the family unit, claiming that it subjugates women. Isn’t a single woman/mother, who is dependent on the government for their necessities, a subjugation? As the Bible tells a woman to submit to her husband, isn’t a woman beholden to entitlements submitting to the government?

The country was started when, at their peril, brave Puritan men and women began reading the Bible against the wishes of the church leaders. They realized that their rights came from God, not from man. I once heard that, many years ago, one was only thought scholarly if one had read the entire Bible. My guess is if the scholars of today, teaching our nation’s children, taught the very same principles etched on those stone tablets of yore, we would see a dramatic decrease of poverty, crime, and brokenness. So, each day when I say my prayers to heal our country, it begins like this, “Are You There God, it’s me Lauri…”